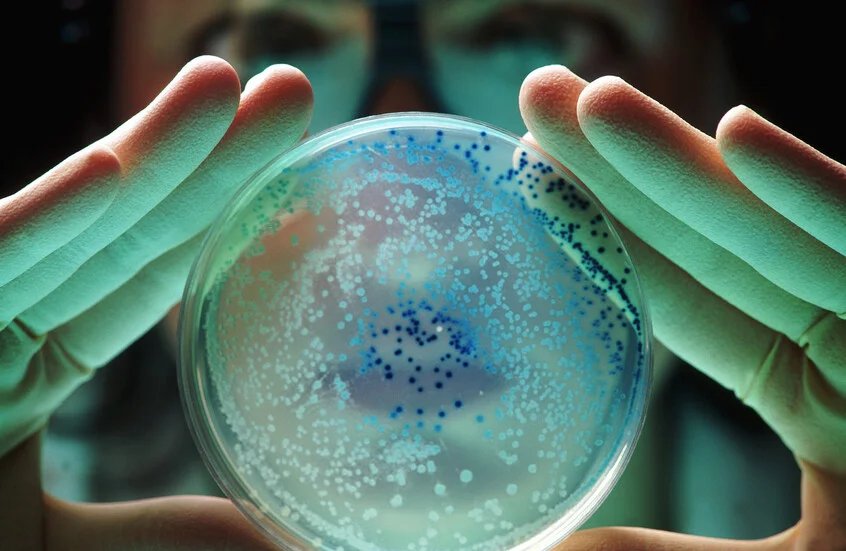

uaetodaynews.com — An Indian experiment reveals the ability of yeast to adapt to the harsh conditions of Mars
Any life on the Red Planet faces extreme challenges such as shock waves from falling meteorites and the soil containing highly oxidizing perchlorates, which destabilize hydrogen bonds and hydrophobic interactions.
The Physical Research Laboratory in Ahmedabad conducted experiments in which the yeast was exposed to shock waves at a speed close to the speed of meteorites, in addition to a concentrated perchlorate substance similar to that found in Martian soil. The cells succeeded in surviving under these stimuli, although the growth rate slowed.
Experiments revealed that the cells formed ribonucleoprotein condensates, which are structures made up of RNA and proteins that protect the RNA from stress and influence its fate. In contrast, mutant strains unable to form these structures did not tolerate the tests well.
The results showed that cells use special protection mechanisms even in very harsh conditions, which is an important step in understanding the possibility of life on Mars and how living organisms adapt to harsh environments.
Source: Naukatv.ru
Disclaimer: This news article has been republished exactly as it appeared on its original source, without any modification.
We do not take any responsibility for its content, which remains solely the responsibility of the original publisher.
Author:
Published on: 2025-10-17 07:04:00
Source: arabic.rt.com
Disclaimer: This news article has been republished exactly as it appeared on its original source, without any modification. We do not take any responsibility for its content, which remains solely the responsibility of the original publisher.
Author: uaetodaynews
Published on: 2025-10-17 03:45:00
Source: uaetodaynews.com